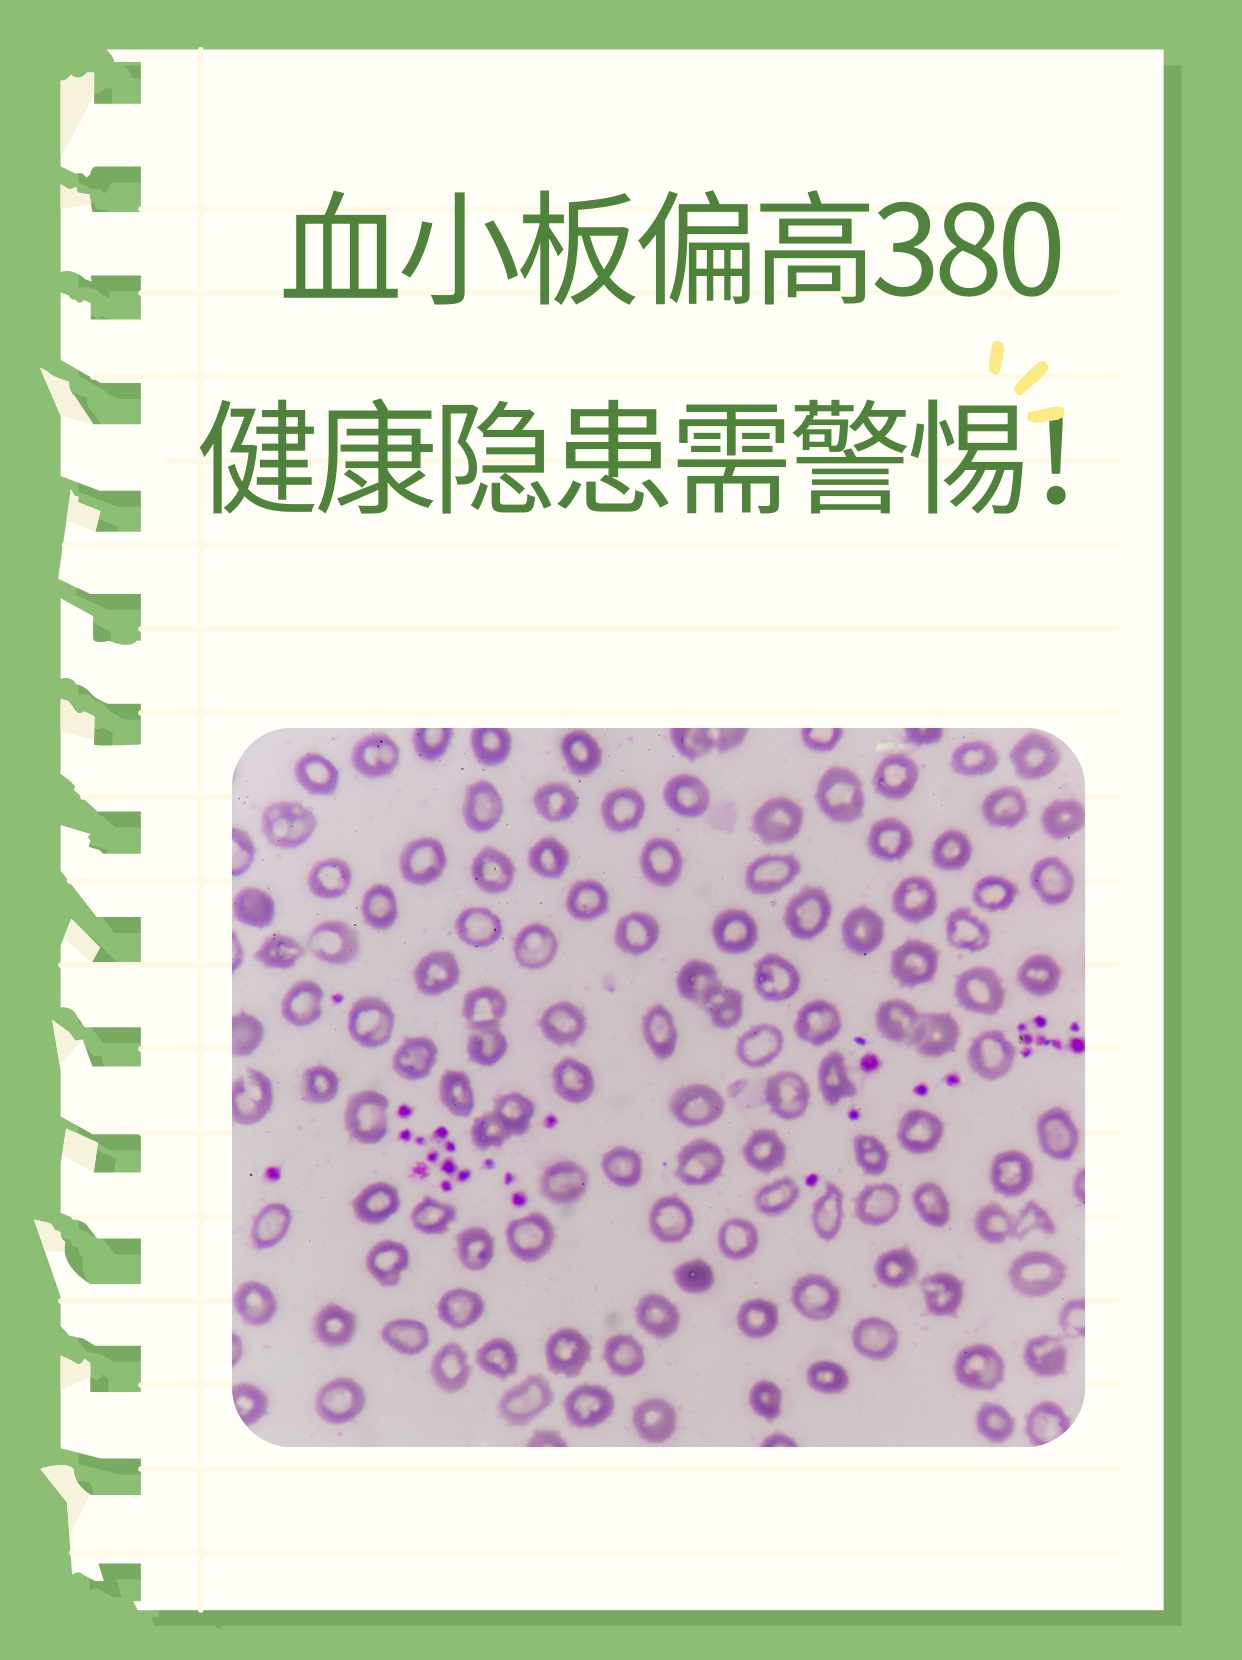

催产针对胎儿有影响吗?(生命有重量 预产期催产或降低胎儿死亡风险)
对于预产期已至却无分娩迹象的孕妇,医院通常会等待1至2周才会催产。英国研究人员最近发现,如果在预产期催产,出现死胎和新生儿死亡的风险会降低。伦敦卫生及热带医学学院研究人员分析了英格兰8万多名高龄初产孕妇的分娩情况,发...
尖锐湿疣潜伏期是多长时间呢?(尖锐湿疣的潜伏期有多长呢)
尖锐湿疣的潜伏期有多长呢作为当前比较常见的疾病之一,尖锐湿疣因为其强大的传染性,已经成为社会的主流型疾病。人们对于尖锐湿疣的认识还远远不够,所以导致很多患者在感染上尖锐湿疣之后都不知道如何是好。那么,尖锐湿疣的潜伏期...
身上有臭味刺鼻,不是狐臭(女子身上不是香的)
不知道你们有没有听过“闻香识女人”,简单地说就是闻女人身上的味道来辨别这个女人的生活态度。女人自带香味是有科学依据的,是女性身上的荷尔蒙,在医学上称为信息素或外激素,与用的化妆品,衣服的味道,还有身体的一些汗腺分泌物...
为什么体检不能喝水?
体检前不能喝水的主要原因是喝水可能会影响体检结果的准确性具体来说影响血糖检测结果喝水时的吞咽行为会反馈到大脑的饥饱中枢,这个过程可能会动员肝糖原分解,释放葡萄糖到血液中,从而导致血糖升高,影响血糖检测的准确性影响肝胆...
氢化可的松琥珀酸钠是什么药(氢化可的松氢化可的松琥珀酸钠修改说明书 过敏者禁用)
新京报讯(记者 王卡拉)3月18日,国家药品监督管理局发布通知,决定对氢化可的松注射液、注射用氢化可的松琥珀酸钠说明书【不良反应】、【注意事项】等项进行修订。其中,对氢化可的松及其他甾体激素的患者禁用上述两种药品,对...
什么是生脉饮啊(每日一味中成药生脉饮)
生脉饮,出自金元时期李杲的《内外伤辨惑论》,又名生脉散。有大补元气,养阴生津、清热除烦,敛肺止汗的功效,可用于气阴两亏、心悸气短、脉微自汗、神疲体倦、咽干口渴、舌红少苔。生脉饮...
血小板计数偏高怎么回事
1、血小板计数偏高可能是由以下原因造成的原发性增多骨髓增生疾病如慢性粒细胞白血病真性红细胞增多症和原发性血小板增多症等骨髓纤维化早期也是导致血小板计数偏高的原因之一继发性血小板增多症出血身体某部位的出血可能导致血小板...
肺部结节吃什么食物好(有肺结节别害怕)
随着现代社会的进步,现在的人们对于健康养生的越来越关注,每年都会定期去体检,生怕自己得了某种疾病,却因为自己的不在乎而到了晚期,做定期检查可以让自己随时了解自己的身体状况。有些人在检查的时候会发现自己得了肺结节,会因...

京公网安备11000000000001号
京ICP备11000001号